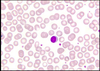

Blood Images Flashcards
Identify the blood cell

Blast
- Large cell
- Large euchromatic nucleus
- More nucleus than cytoplasm
- Cytoplasm is pale blue with no graules
Identify the blood cell

Blast
- Large cell
- Large euchromatic nucleus
- More nucleus than cytoplasm
- Cytoplasm is pale blue with no graules
Identify the blood cell

Blast
- Large cell
- Large euchromatic nucleus
- More nucleus than cytoplasm
- Cytoplasm is pale blue with no graules
Identify the blood cell

Basophilic erythroblast (BE)
- Smaller than blast
- Nucleus: checkerboard appearance of chromatin
- Navy blue cytoplasm
Identify the blood cell

Basophilic erythroblast
- Smaller than blast
- Nucleus: checkerboard appearance of chromatin
- Navy blue cytoplasm
Identify the blood cell

Basophilic erythroblast
- Smaller than blast
- Nucleus: checkerboard appearance of chromatin
- Navy blue cytoplasm
Identify the blood cells (two arrows are same type)

Two polychromatophilic erythroblasts
- Smaller than BE
- Condesed chromatin
- Cytoplasm now pink (was blue in earlier stages)
Identify the blood cell

Two polychromatophilic erythroblasts
- Smaller than BE
- Condesed chromatin
- Cytoplasm now pink (was blue in earlier stages)
Identify the two blood cells

- Early polychromatophilic erythroblast
- Later polychromatophilic erythroblast
- Smaller than BE
- Condesed chromatin
- Cytoplasm now pink (was blue in earlier stages)
Identify the blood cell

Late polychromatophilic erythroblast
- Smaller than BE
- Condesed chromatin
- Cytoplasm now pink (was blue in earlier stages)
Identify the blood cell

Normoblast
- Smaller than polychromatic erythroblast
- Totally heterochrmoatic nucleus
- Cytoplasm is mostly pink, hint of blue
- No longer capable of mitosis!
Identify the blood cell

Orthochromatic erythroblast
Identify the blood cell

Orthochromatic erythroblast
Identify the blood cell

Reticular cell
- Large cells
- Lots of ingested material in cytoplasm
- Large pale staining nucleus
Identify

Erythroblastic Island (EBI)
- Polychromatophilic erythroblasts clustered around reticular cells
Identify the blood cell

Plasma cell
- Blue cytoplasm
- Eccentrically placed nucleus with “clockface” distribution of chromatin
Identify the blood cell

Megakaryoblast (MB)
- Large cell
- Oval or spherical nucleus
- Blue cytoplasm
- First step in platelet differentiation
Identify the blood cell

Megakaryocyte
- Larger than megakaryoblasts
- Lobulated nucleus
- Invaginations of plasma membrane
- Pink cytoplasm with azurophilic granules
- Second stage of plasma differentiation
Identify the blood cell

Neutrophilic promyelocyte
- Large cell (same size as blast)
- Spherical nucleus, slight chromatin condensation
- Cytoplasmic granules (azurophilic)
- Second stage in neutrophil differentiation
Identify the two blood cell types

Neutrophilic myelocyte
- Round/oval nucelus, darker
- Secondary granules in cytoplasm (azurophilic decrease)
- DNA rep/RNA syn decreases so chromatin becomes more condensed and blue cyto decreases
- 3rd stage in neutrophil differentiation
5 polychromatophilic erythroblasts
Identify the blood cell

Neutrophilic metamyelocyte
- Indented nucleus
- Condensed chromatin
- Salmon-pink cytoplasm with secondary granules
- Not capable of mitosis
Identify the two types of blood cells

- Developing eosinophil
- Large cytoplasmic granules
- Turn from black to pink/red - Neutrophilic promyelocyte
- Large cell (same size as blast)
- Spherical nucleus, slight chromatin condensation
- Cytoplasmic granules (azurophilic)
- Second stage in neutrophil differentiation

Identify the blood cell

Basophil
- Large granules that stain purple
Identify the blood cell

Neutrophilic band
- Indentation of nucelus exceeds 1/2
- Condensed chromatin
- Incapable of mitosis
5th stage in neutrophil differentiation